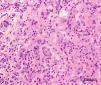

Mujer de 25 años de edad que refería una tumoración no dolorosa amarillenta en el ojo derecho. Su agudeza visual era de la unidad. En la exploración en lámpara de hendidura se observa una masa amarilla-anaranjada localizada en el limbo superior del ojo derecho. No se observaron otras anormalidades.
DiscusiónSe realizó una escisión quirúrgica de la lesión y se remitió a anatomía patológica para su examen. La lesión granulomatosa mostraba células de Touton. Este hecho sugiere de forma importante el diagnóstico de xantogranuloma juvenil (JXG). La afectación ocular ocurre en el 10% de los casos de JXG.
A 25-year-old woman noticed a painless yellow-orange mass on her right eye. Her visual acuity was 20/20 in both eyes, and a slit-lamp examination showed a yellow-orange mass located at the superior limbus of the right eye. No other ocular abnormalities were observed.
DiscussionSurgical excision was carried out and the lesion was sent for histological examination. This showed a granulomatous lesion, rich in Touton-type giant cells, features that are strongly suggestive of juvenile xanthogranuloma (JXG). Ocular involvement occurs in 10% of cases of JXG.